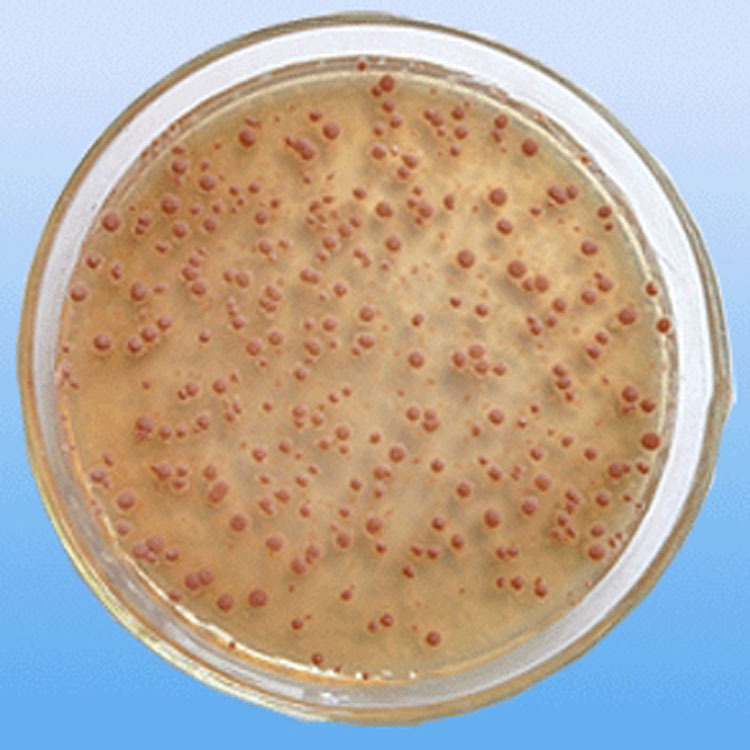
硝化细菌微生物水产养殖水质调控底质改良 降解氨氮 反硝化细菌

硝化细菌

硝化细菌是生产者还是消费者?
图片尺寸423x289
硝化细菌应该属于什么型的微生物呢
图片尺寸640x331
硝化细菌应该属于什么型的微生物呢
图片尺寸640x320
为什么我的硝化细菌这样子
图片尺寸828x1104
宝藏水质剂96,鱼儿快乐滋长!我的全新安利——硝化细菌活菌 - 抖音
图片尺寸1020x1360
误区新手使用硝化细菌最容易犯的3个错误
图片尺寸928x686
水质净化菌剂——硝化细菌
图片尺寸420x354
硝化细菌需要光照吗硝化细菌的使用方法
图片尺寸600x400
硝化细菌的自白读完了你就是循环水养殖系统设计专家
图片尺寸580x430
宣歌鱼缸水族箱观赏鱼硝化细菌硝化菌干粉 硝化细菌胶囊 净化水质
图片尺寸790x1365
请教这些是什么是硝化细菌吗
图片尺寸1984x1488
硝化细菌对鱼有害吗
图片尺寸739x489
硝化细菌污水处理 污水处理厂专用菌固氮除臭,底质改良用菌
图片尺寸1768x1755
完善的水族生态系统只是个天方夜谭_硝化细菌_亚硝酸_阶段
图片尺寸784x527
硝化细菌下粉状的还是液态的
图片尺寸1200x868
硝化细菌微生物水产养殖水质调控底质改良 降解氨氮 反硝化细菌
图片尺寸750x750
硝化细菌可以净化水质吗它在过滤系统中起什么作用
图片尺寸500x323
水族箱硝化细菌胶囊鱼缸硝化细菌消化细菌干粉硝化菌龙鱼及魟鱼100粒
图片尺寸790x773
原创养鱼学堂硝化细菌的自白
图片尺寸593x357
硝化细菌可以净化水质吗它在过滤系统中起什么作用
图片尺寸600x457